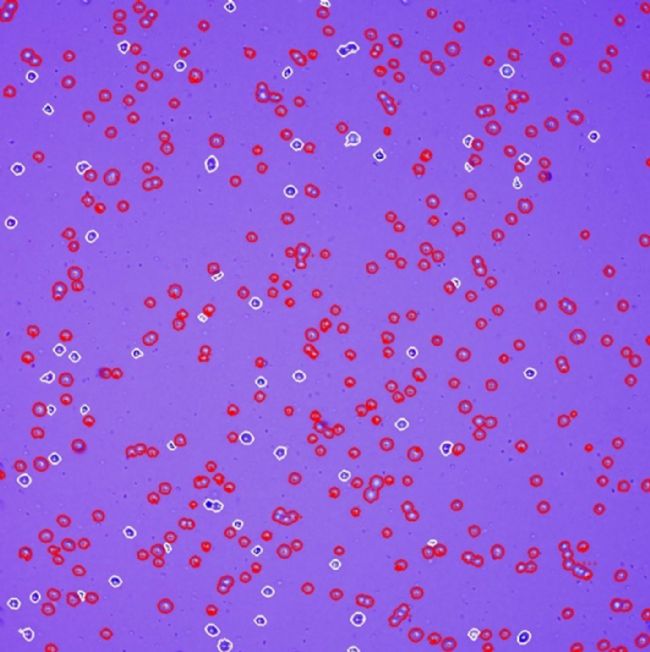
DƬ7.jpg

一臺高性價比的儀器應更具包容性,
一機多用、功能強大、成像清晰,
對特殊樣本也很友好。

JSY-SC-031N型全自動細胞計數儀,
是一款內置高倍放大光學系統的一體式明場細胞計數儀,
尤其適合對直徑較小的細胞標本進行精準計數。
參照“血細胞計數板”計數標準,采用四個區域結果統計,
具有“非染色”“染色”“人工比對”三種計數模式,能自動實現細胞活率計數。
【一次性細胞計數片計數效果】
-球藻細胞-
031N拍照和識別效果1/4視野(非染色模式)

細胞原始圖 細胞識別圖
注:該細胞直徑為2-10微米
-透明微球-
031N拍照和識別效果1/4視野(非染色模式)

細胞原始圖 細胞識別圖
注:透明微球直徑約8微米
-外周血單個核細胞PBMC-
031N拍照和識別效果1/4視野(臺盼藍染色模式)
細胞原始圖 細胞識別圖
注:該細胞直徑3-9微米
【血球計數板計數效果】
標準的血球計數板是有刻線的
用了這個功能,不僅所見即所得
還和顯微鏡人工計數的過程一致
-球藻細胞-
031N拍照和識別效果1/4視野(非染色模式)

細胞原始圖 細胞識別圖
-免疫細胞-
031N拍照和識別效果1/4視野(臺盼藍染色模式)

細胞原始圖 細胞識別圖
-昆蟲細胞-
031N拍照和識別效果1/4視野(臺盼藍染色模式)

細胞原始圖 細胞識別圖
-球蟲和線蟲
031N拍照和識別效果5/21視野(非染色模式)



注:031N可以實現21個區域自動掃描拍照,拍攝多張清晰圖片
小機型,大能量!
看得見,更相信!